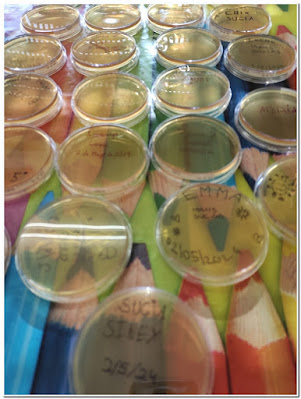

Esta mañá tivemos a sorte de escoitar a Paula Río, científica e investigadora ferrolá, doutora en Ciencias Biolóxicas, que na actualidade, despois dun longo periplo, está traballando en Madrid, na Unidade de Innovación Biomédica (CIEMAT), no estudo e tratamento de enfermidades raras relacionadas co sangue, en concreto, o caso da Anemia de Fanconi.
Logo subimos ao laboratorio e alí fixemos dúas prácticas:
Deixamos as nosas pegadas de mans limpas ou mans sucias nunha placa de Petri para ver tooodo o que pode aparecer alí nunha semana máis ou menos, xa vos contaremos!
E tamén puidemos extraer o ADN dun plátano! Marabilloso!
Moitas grazas á familia de Elisa B., por facer posible este encontro e por supostísimo, a Paula Río.
Unha experiencia fabulosa para sumar!
Preme nesta última foto para acceder ao álbum completo.

Ningún comentario:
Publicar un comentario